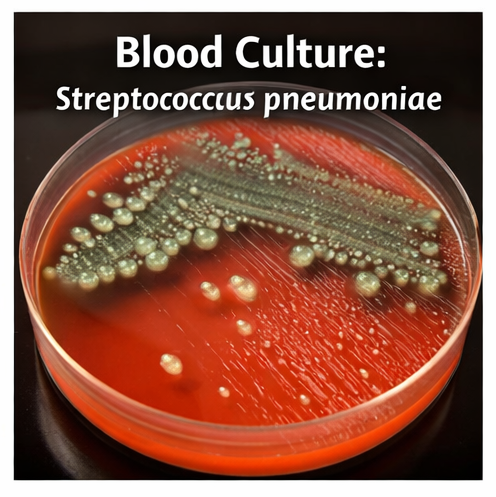

Septic shock is a life-threatening manifestation of sepsis characterized by profound circulatory, cellular, and metabolic abnormalities, leading to high mortality if not promptly recognized and treated. Early identification, rapid source control, appropriate antimicrobial therapy, and aggressive hemodynamic resuscitation are critical determinants of patient outcomes. We report a case of a middle-aged male presenting with fever, hypotension, altered sensorium, and multiorgan dysfunction secondary to community-acquired pneumonia complicated by septic shock. This case highlights clinical presentation, diagnostic evaluation, hemodynamic assessment, intensive care management including early goal-directed therapy, vasopressor support, antimicrobial treatment, and short-term outcomes. The report underscores the importance of early sepsis recognition, adherence to sepsis bundles, timely escalation of care, and structured follow-up to improve survival and reduce long-term morbidity.
Sepsis is defined as life-threatening organ dysfunction caused by a dysregulated host response to infection, while septic shock represents a subset of sepsis with profound circulatory and metabolic abnormalities associated with a significantly higher risk of mortality. Despite advances in critical care, septic shock remains a major global cause of morbidity and mortality. Common sources include pneumonia, urinary tract infections, intra-abdominal infections, and bloodstream infections. Early diagnosis and prompt implementation of evidence-based management, including fluid resuscitation, early broad-spectrum antibiotics, vasopressor therapy, and source control, are essential to improve outcomes. This report presents the clinical course, diagnostic challenges, management strategy, and outcome of a patient with septic shock.
A 58-year-old male with a known history of type 2 diabetes mellitus and hypertension presented to the emergency department with a 2-day history of high-grade fever, productive cough, shortness of breath, and progressive drowsiness. The patient reported reduced urine output over the preceding 12 hours. There was no recent history of hospitalization or invasive procedures. No history of chronic lung disease or immunosuppressive therapy was noted.
On presentation, the patient was ill-appearing and confused. Vital signs revealed hypotension (BP 78/46 mmHg), tachycardia (HR 126/min), tachypnea (RR 32/min), fever (39.4°C), and oxygen saturation of 88% on room air.

Peripheral perfusion was poor with cold extremities and delayed capillary refill. Lung auscultation revealed coarse crackles over the right lower lung fields. The patient had altered mental status (GCS 12/15) and reduced urine output (<0.3 mL/kg/hour).
• Septic shock secondary to severe community-acquired pneumonia
• Acute respiratory distress syndrome (ARDS)
• Acute decompensated heart failure
• Pulmonary embolism
• Severe dehydration with hypovolemic shock
Initial laboratory evaluation showed leukocytosis (18,400 cells/mm³), elevated serum lactate (4.8 mmol/L), elevated C-reactive protein and procalcitonin, acute kidney injury (serum creatinine 2.1 mg/dL), and metabolic acidosis.

Arterial blood gas analysis revealed hypoxemia and lactic acidosis. Chest radiograph demonstrated right lower lobe consolidation consistent with pneumonia.

Blood cultures and sputum cultures were obtained prior to antibiotic administration.
Bedside ultrasound revealed a collapsible inferior vena cava suggestive of intravascular volume depletion and no evidence of cardiac tamponade. The patient met Sepsis-3 criteria for septic shock, with persistent hypotension requiring vasopressors to maintain mean arterial pressure (MAP) ≥65 mmHg and serum lactate >2 mmol/L despite adequate fluid resuscitation.
Immediate management followed sepsis bundle protocols. The patient received rapid intravenous crystalloid resuscitation (30 mL/kg within the first 3 hours). Broad-spectrum empiric intravenous antibiotics (piperacillin-tazobactam plus azithromycin) were initiated within one hour of recognition of septic shock. Norepinephrine infusion was started due to persistent hypotension after fluid resuscitation to maintain MAP ≥65 mmHg. Supplemental oxygen was provided, and the patient was shifted to the intensive care unit (ICU) for close hemodynamic monitoring.

Blood glucose was controlled with insulin infusion. Early source control was achieved with targeted antimicrobial therapy once cultures later grew Streptococcus pneumoniae, and antibiotics were de-escalated accordingly. Supportive care included strict fluid balance monitoring, renal function surveillance, venous thromboembolism prophylaxis, stress ulcer prophylaxis, and nutritional support.
Over the next 72 hours, the patient showed gradual hemodynamic stabilization with decreasing vasopressor requirements and improving lactate levels. Renal function normalized with supportive management, and oxygen requirements reduced with improvement in respiratory status. The patient was weaned off vasopressors by day 4 and transferred out of the ICU on day 6. He completed a 7-day course of targeted antibiotics and was discharged in stable condition on day 10.
At 4-week follow-up, the patient had recovered well with no residual organ dysfunction. He was counseled regarding early recognition of infection, glycemic control, vaccination against pneumococcus and influenza, and the importance of seeking early medical care for febrile illnesses. Structured follow-up was advised to monitor for post-sepsis syndrome, functional recovery, and recurrence risk.

Septic shock represents the most severe end of the sepsis spectrum and is associated with high short-term and long-term mortality. Prognosis depends on early recognition, rapid initiation of appropriate antimicrobial therapy, timely fluid resuscitation, vasopressor support, and effective source control. Elevated serum lactate reflects tissue hypoperfusion and is a strong prognostic marker guiding resuscitation efforts.
Early administration of broad-spectrum antibiotics within the first hour of recognition is one of the most important modifiable determinants of survival. Norepinephrine remains the first-line vasopressor for maintaining adequate MAP, while dynamic assessment of fluid responsiveness helps avoid fluid overload. Adjunctive supportive care, including organ support, glycemic control, and prevention of ICU-related complications, is critical in reducing morbidity.
Post-sepsis morbidity, including physical deconditioning, cognitive impairment, and psychological sequelae, is increasingly recognized, emphasizing the importance of structured follow-up and rehabilitation. A multidisciplinary approach involving emergency physicians, intensivists, infectious disease specialists, and nursing teams is essential for optimizing outcomes in septic shock.
Septic shock is a medical emergency requiring rapid diagnosis, prompt antimicrobial therapy, aggressive hemodynamic resuscitation, and early ICU management to reduce mortality. Adherence to evidence-based sepsis bundles, timely source control, and continuous monitoring of organ function are central to improving outcomes. Long-term follow-up is essential to address post-sepsis sequelae, optimize recovery, and reduce the risk of recurrent infections. Multidisciplinary coordination and patient education play vital roles in ensuring continuity of care and improving survival and quality of life following septic shock.
Read more such content on @ Hidoc Dr | Medical Learning App for Doctors
1.
Potential targets for treating the most common type of liver cancer in children have been identified by a collaborative study.
2.
Study identifies new approach to protect the brain during radiation therapy
3.
While most cancer screenings won't prolong lives, there are still good reasons to continue screening.
4.
Chemo-Free Quadruplet Shows Promise as DLBCL's First Therapy.
5.
Radiation therapy for patients with breast cancer
1.
Radiation in Oncology: Advances, Applications, and Accessibility
2.
The Next Generation of Precision: How Multi-Specific Antibodies are Redefining Oncology's Future - A 2025 Review
3.
Cracking Oncology Drug Resistance: New Strategies to Overcome Challenges in Modern Cancer Therapy
4.
Unlocking the Secrets of Neutrophils: Exploring Their Role in Immune Defense
5.
Precision Oncology: Personalized Medicine Shaping the Future of Cancer Care
1.
International Lung Cancer Congress®
2.
Genito-Urinary Oncology Summit 2026
3.
Future NRG Oncology Meeting
4.
ISMB 2026 (Intelligent Systems for Molecular Biology)
5.
Annual International Congress on the Future of Breast Cancer East
1.
Pazopanib Takes Center Stage in Managing Renal Cell Carcinoma - Part II
2.
Recent Data Analysis for First-Line Treatment of ALK+ NSCLC
3.
Navigating the Complexities of Ph Negative ALL - Part XIII
4.
Navigating the Complexities of Ph Negative ALL - Part IV
5.
Revolutionizing Treatment of ALK Rearranged NSCLC with Lorlatinib - Part VIII
© Copyright 2026 Hidoc Dr. Inc.
Terms & Conditions - LLP | Inc. | Privacy Policy - LLP | Inc. | Account Deactivation